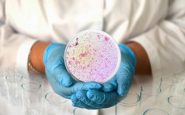
featured 1966484

Milano, 10 giu. (Adnkronos Salute) – In Europa è allarme 'super gonorrea'. Nel Vecchio continente aumentano con un "trend preoccupante" i casi di malattia, un'infezione a trasmissione sessuale, resistenti agli antibiotici usati per curarla. E' quanto emerge da un rapporto dell'Ecdc, Centro europeo per la prevenzione e il controllo delle malattie, che in base agli ultimi dati del Programma europeo di sorveglianza antimicrobica gonococcica (Euro-Gasp) sottolinea "la necessità fondamentale di un monitoraggio continuo per aggiornare le linee guida sul trattamento e le misure di controllo, e garantire un uso prudente dei farmaci" in un contesto con cifre da record.
"Nel 2022 – informa l'Ecdc – sono stati segnalati 70.881 casi confermati di gonorrea in 28 Paesi di Unione europea e Spazio economico europeo, con un incremento del 48% rispetto al 2021. Nel 2022, in Ue/See, il tasso di notifica per la gonorrea è il più alto registrato da quando nel 2009 è iniziata la sorveglianza europea sulle infezioni sessualmente trasmissibili", evidenziano gli esperti.
Allarmati per i numeri della patologia, ma anche per la sua crescente 'invulnerabilità' alle cure.
Su un totale di 4.396 campioni prelevati da pazienti con diagnosi di gonorrea, analizzati nel 2022 da 23 Paesi nell'ambito del programma di sorveglianza, spiccano "2 isolati di Neisseria gonorrhoeae resistenti al ceftriaxone, l'antibiotico raccomandato per il trattamento della gonorrea.
Questi ceppi batterici – avverte l'Ecdc – hanno mostrato anche un'ampia resistenza ai farmaci (Xdr) e una resistenza multifarmaco (Mdr)", caratteristiche "che limitano ulteriormente le opzioni terapeutiche". Non solo: tra il 2021 e il 2022 "la percentuale di isolati resistenti all'azitromicina è aumentata significativamente dal 14,2% al 25,6%". Un dato ritenuto "particolarmente preoccupante", considerando che "l'azitromicina è spesso utilizzata con ceftriaxone per trattare la gonorrea". Nello stesso periodo "anche la resistenza alla ciprofloxacina è cresciuta, dal 62,8% al 65,9%". E "sebbene la resistenza a cefixime rimanga bassa (0,3%), il monitoraggio continuo è fondamentale – ammonisce l'agenzia – in particolare perché i ceppi gonococcici resistenti a cefixime e ceftriaxone si stanno diffondendo a livello internazionale".
"Sebbene la maggior parte delle infezioni da gonorrea nell'Ue/See rimangano curabili con gli antibiotici attualmente raccomandati, le tendenze crescenti di antibiotico-resistenza sono preoccupanti e richiedono una maggiore vigilanza", scrive l'Ecdc. "L'aumento dei ceppi resistenti – spiegano gli esperti – può compromettere l'efficacia delle opzioni terapeutiche esistenti, ponendo una sfida significativa per la salute pubblica fino a quando non saranno disponibili nuovi farmaci".
L'agenzia invita dunque a mettere in atto "una sorveglianza rafforzata, continua e allargata, di qualità garantita, sulla sensibilità antimicrobica, per rilevare tempestivamente i modelli di resistenza", e a "rivedere e aggiornare periodicamente le linee guida terapeutiche in base ai più recenti dati di sorveglianza sulla resistenza antimicrobica, così da assicurare la disponibilità dei trattamenti più efficaci". E' inoltre "fondamentale investire nello sviluppo di nuovi antibiotici e regimi terapeutici alternativi". Ma serve anche "rafforzare le iniziative di sanità pubblica volte a prevenire la diffusione della gonorrea, compreso un maggiore accesso ai servizi diagnostici", e "promuovere la cooperazione internazionale per contribuire al monitoraggio e al controllo della diffusione di ceppi resistenti" da un Paese all'altro.
Gli esperti insistono sull'importanza della "prevenzione per frenare la diffusione della gonorrea e mitigare il rischio di resistenza antimicrobica": praticare sesso sicuro, sottoporsi a test per la diagnosi delle infezioni sessualmente trasmissibili, evitare il 'fai da te' nell'assunzione di antibiotici (non consumare farmaci non necessari e non interrompere quelli prescritti), ripetere i test per verificare il successo della cura.